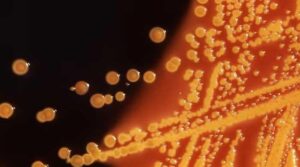
کم عمر بالغوں میں کولوریکل اور دیگر معدے کے کینسر کیوں بڑھ رہے ہیں؟

محققین گھاس بخار کو دور کرنے کے لئے نئی ‘ناک مالیکیولر شیلڈ’ تیار کرتے ہیں
یہ نمائندگی کی شبیہہ ایک شخص کو الرجی کے علامات کا سامنا کرنے والے شخص کو ظاہر کرتی ہے۔ – پکسابے گھاس بخار کے مریضوں

یہ نمائندگی کی شبیہہ ایک شخص کو الرجی کے علامات کا سامنا کرنے والے شخص کو ظاہر کرتی ہے۔ – پکسابے گھاس بخار کے مریضوں

8 مئی ، 2019 کو لی گئی اس تصویر میں ، ایک پاکستانی ڈاکٹر ایک سرکاری زیر انتظام اسپتال میں ایچ آئی وی ٹیسٹ کے
ای کولی کے بیکٹیریا کی کالونیوں کو ایک مائکروسکوپک میں ہیکوٹین انٹرک (ایچ ای) ایگر پلیٹ میں اگایا جاتا ہے۔ – سی ڈی سی/رائٹرز/فائل صحت

اوشین سائیڈ ، کیلیفورنیا ، امریکہ ، 29 اپریل ، 2020 میں گیلاد سائنسز۔ – رائٹرز ہیلتھ فنانسنگ گروپ نے بدھ کے روز کہا کہ

ان پر لکھے ہوئے محرک الفاظ کے ساتھ پوسٹ نوٹ کی نمائندگی کی تصویر۔ – unsplash جیو ڈاٹ ٹی وی مثال پیارے مکھی ، میں

اس نمائندگی کی تصویر میں ایک عورت کو یوگا کرنے میں دکھایا گیا ہے۔ – unsplash یونیورسٹی کالج لندن (یو سی ایل) کی ایک نئی

چیف منسٹر مریم نواز نے 4 جولائی ، 2025 کو ڈسٹرکٹ ہیڈ کوارٹر اسپتال (ڈی ایچ کیو) پاکپٹن ، پنجاب کا حیرت زائرین کا دورہ

نیشنل انسٹی ٹیوٹ آف کارڈیواسکولر بیماری (این آئی سی وی ڈی) کراچی میں عمارت۔ – فیس بک/نیک وی ڈی آزرا پیچوہو نے نوٹس لیا ،

14 نومبر ، 2012 کو کیلیفورنیا کے سان ڈیاگو میں ٹوری پائنس اسٹیٹ پارک میں لوگ واک اور سیر کرتے ہیں۔ – رائٹرز ٹائپ 2

یوروپی یونین چین تجارتی تناؤ میں تازہ ترین سالوو میں سرجیکل ماسک سے لے کر ایکس رے مشینوں تک صحت کی دیکھ بھال کی فراہمی